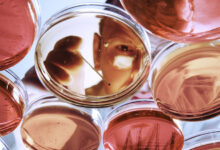

Новости
Трамп поддержал лидера Ливана в вопросе прекращения огня с Израилем
Президент США Дональд Трамп поддержал ливанского лидера Джозефа Ауна в вопросе скорейшего прекращения огня с Израилем.

- Gettyimages.ru
«Трамп… подтвердил свою поддержку Ауну и Ливану, подчеркнув приверженность удовлетворению ливанского запроса о прекращении огня в максимально короткие сроки», — говорится в заявлении канцелярии ливанского президента в соцсети X.
Сегодня, 16 апреля, состоялся телефонный разговор между Трампом и Ауном. В ходе беседы ливанский лидер вновь поблагодарил президента США за усилия по достижению прекращения огня в Ливане и обеспечении долгосрочного мира и стабильности как шага к запуску мирного процесса в регионе.
Нажмите, чтобы оценить статью!
[Итого: 0 Среднее значение: 0]